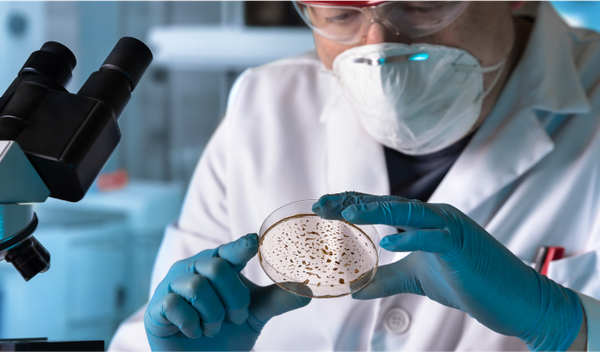
Image for Ahilova peta najopasnijih bakterija?

Nova otkrića: multipla skleroza može se otkriti godinama pre prvih simptoma
Multipla skleroza (MS) je hronična neurološka bolest koja tri puta češće pogađa žene nego muškarce. Najčešće se dijagnostikuje tek kada se pojave prvi simptomi, ali novo istraživanje pokazuje da bi bolest mogla da se prepozna i mnogo ranije – čak i godinama pre nego što se klinički ispolji.